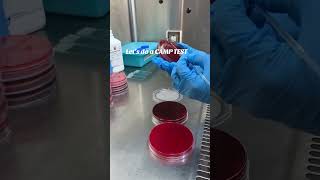

CAMP test for Streptococcus agalactiae GBS and Listeria (Microbiology) video
Online izle ve mp4 mp3 formatlarinda yukle
Videonun muddeti: SHORTS
CAMP test for Streptococcus agalactiae GBS and Listeria (Microbiology) videosu mp4 ve mp3 yuklemek ucun hazirdir
Diqqet! Siz Mp4 yukle ve ya Mp3 yukle duymesine basdiqdan sonra eger sistem sizi reklam sehifesine atarsa o zaman derhal geri qayidib emeliyyati tekrar edin ve faylin yuklemek ucun hazir olmasini gozleyin
Videodan Mp4 Yukle
Videodan Mp3 Yukle-1
Videodan Mp3 Yukle-2
Oxshar Axtarishlar
CAMP test for Streptococcus agalactiae - GBS and Listeria (Microbiology)
Streptococcus agalactiae (group B strep) - an Osmosis Preview
Why & What is CAMP Test ? ( Clear Explain )
Camp Test
CAMP test Streptococcus agalactiae - Microbiology
CAMP test for Streptococcus agalactiae - GBS
Streptococcus Agalactiae
CAMP test
Strep Species Explained FAST | Strep pyogenes, GBS, Pneumococcus & Viridans
Video Mp4 Mp3Azwap.Biz
Azwap.Biz 2021-2023